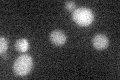
YDR038C

View description
Protein with similarity to P-type ATPase sodium pumps, member of the Na+ efflux ATPase family
Localization:
Intensity:
Fold change:
Significance:
-
C’ GFP library in SD
below threshold18.03 -
N' NOP1pr-GFP in SD

cell periphery,vacuole93.3594 -
N' TEF2pr-mCherry in SD

below threshold6.53209 -
N' NATIVEpr-GFP in SD

below threshold17.8555 -
N' TEF2pr-VC and Cyto-VN in SD

ER32.098 -
C’ GFP library in SD+DTT

cytosol16.860.93No -
C’ GFP library in SD+H2O2

cytosol16.680.92No -
C’ GFP library in Starvation Media

cytosol170.94No -
C’ GFP library on the background of Pup2-DaMP

below threshold -
C’ GFP library on the background of CCT mutant

below threshold16.33460.905782No
